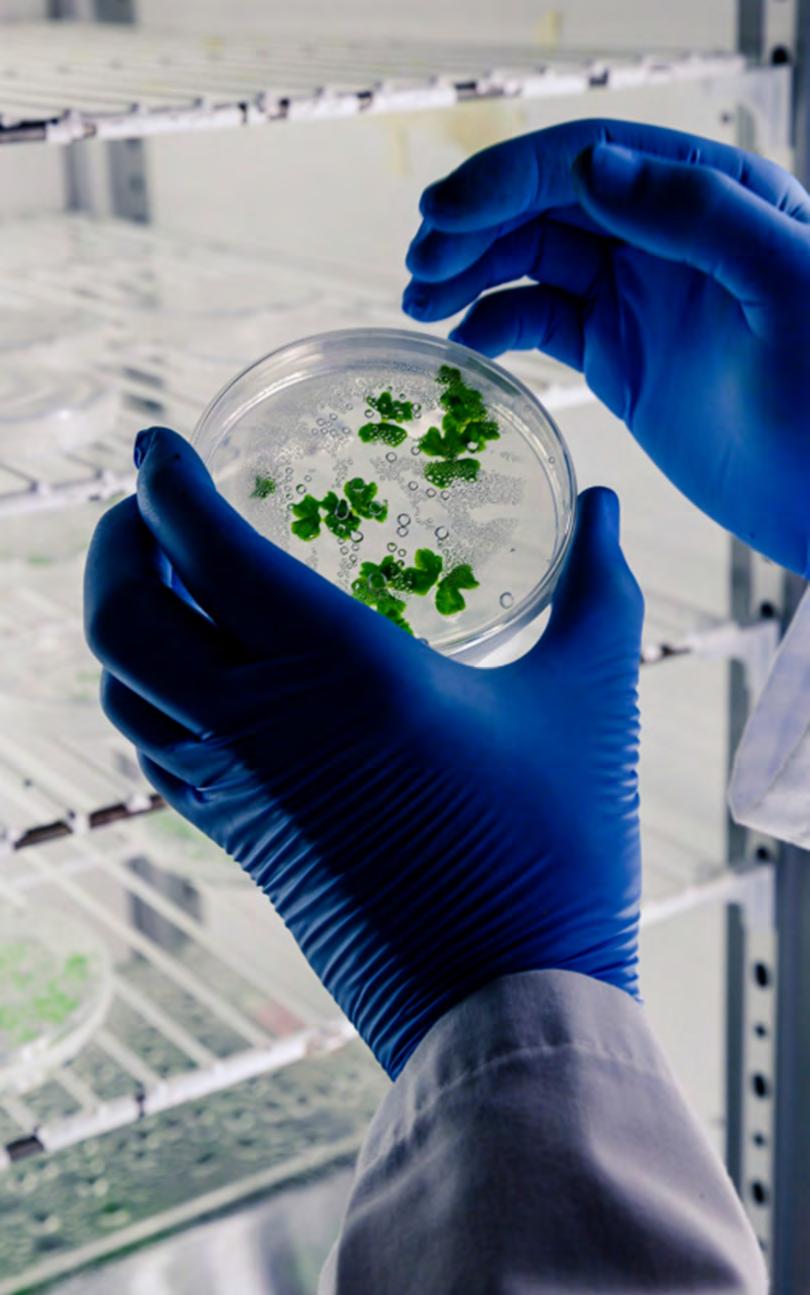

Funcionaria municipal vinculada al Tren de Aragua
3 Trabaja en la Oficina de Migración de San Felipe y tendría nexos con la organización criminal

Trató de sobornar a carabinero con $20 mil pesos


![]()
3 Trabaja en la Oficina de Migración de San Felipe y tendría nexos con la organización criminal

Trató de sobornar a carabinero con $20 mil pesos


Vehículos permitirán garantizar el acceso a la educación de estudiantes de sectores alejados
En una medida ampliamente valorada por la comunidad educativa, el Concejo Municipal de La Cruz aprobó por unanimidad la adquisición de tres nuevos taxibuses para el traslado gratuito de estudiantes de la comuna. La iniciativa, gestionada por la alcaldesa Filomena Navia y su equipo técnico, busca mejorar la asistencia escolar y facilitar el acceso a los establecimientos educacionales, especialmente en sectores rurales y de difícil conectividad.
El director del Departamento de Educación Municipal (DAEM), Roberto Bustamante, señaló que ya se adjudicó la compra de los vehículos a la empresa seleccionada mediante licitación pública. Actualmente, se está a la espera de su llegada, mientras se avanza en la etapa de selección final de conductores, quienes deberán rendir pruebas de conducción para incorporarse a la planta municipal.
Además, se definieron recorridos preliminares que cubrirán distintos sectores de la comuna y conectarán con establecimientos como el Colegio Bolonia, Colegio María Alonso Chacón, Liceo San Isidro, Liceo Técnico Agrícola Raúl Lira Infante y Colegio Leonardo Da Vinci, entre otros.
“Esperamos que estos móviles tengan un impacto impor-
tante en la asistencia, sobre todo en esta época de invierno, donde ha sido muy difícil para muchos niños llegar a sus escuelas”, afirmó Bustamante, quien también destacó la elaboración de un reglamento de uso y conducta para los estudiantes beneficiarios.
Por su parte, la alcaldesa Filomena Navia agradeció al equipo de la Secretaría Comunal de Planificación (Secplan) por la preparación técnica del proyecto
y expresó su esperanza de que esta inversión signifique un real alivio para las familias de La Cruz, que muchas veces deben enfrentar dificultades económicas y de transporte para que sus hijos puedan estudiar.
“Efectivamente aquí se van a trasladar nuestras infancias y adolescencias, por lo tanto esperamos que sea de mucho beneficio para nuestras familias y por supuesto para nuestros y nuestras estudiantes”, puntualizó.


Se trata de una ciudadana venezolana que trabaja en la Oficina Municipal de Migración
L a municipalidad de San Felipe, confirmó este lunes que, en el marco de detenciones que realizó la PDI por personas vinculadas al tren de Aragua en la región de Valparaíso, hay una funcionaria municipal involucrada, quien fue detenida junto a su madre, por nexos económicos de esta organización criminal internacional.
S e trata de una funcionaria de la Oficina de Migración de la Municipalidad de San Felipe, de iniciales J.R.C., que según las primeras informaciones, junto a su madre habrían figurado como titulares de cuentas bancarias utilizadas para transferir dinero al extranjero, proveniente de actividades ilícitas, en el marco de una eventual red de lavado de activos.
En este sentido, el Director Jurídico de la Municipalidad de San Felipe, abogado Juan
Castro, detalló en un video que este procedimiento se habría desarrollado hace algunas semanas y que recientemente se habrían percatado del vínculo de la funcionaria, tras la información entregada por la encargada de la Oficina de Migración, quien detectó irregularidades tras el período en que la mujer se encontraba con permiso de vacaciones.
“Frente a eso, y considerando que no se presentó a trabajar al término de su feriado, se instruyó una investigación administrativa por orden de la señora alcaldesa, con el fin de aclarar los hechos irregulares que eventualmente pudieran haber ocurrido”, señaló el abogado municipal.
Cabe mencionar que las detenciones de estas dos mujeres en San Felipe, se produjeron en el marco de un mega operativo a nivel nacional, llevado a cabo durante el mes de junio por la PDI y la Fiscalia Regional de Tarapacá, en la que 52 personas


El Director Jurídico de la Municipalidad de San Felipe, abogado Juan Castro, detalló en un video que este procedimiento se habría desarrollado hace algunas semanas.
fueron aprehendidas como sospechosas de integrar una arista económica del Tren de Aragua. De los 52 detenidos, hay 45 venezolanos y siete chilenos, quienes fueron puestos a disposición de la justicia por sacar unos 13,5 millones de dólares del país, al transferirlos hacia cuentas comerciales o bancarias, e incluso intercambiándolo por criptomonedas.
El dinero, que era obtenido por la célula delictual mediante secuestros, extorsiones, narcotráfico y estafas telefónicas, posteriormente era enviado posteriormente por estos intermediarios a países como Colombia, México, España, EE.UU., Paraguay, Argentina y Venezuela. De los aprehendidos extranjeros, 29 se encontraban en situación migratoria regular, mientras que 16 eran irregulares.
El presunto autor de las amenazas tiene antecedentes en su prontuario policial por otros delitos
Personal de la Tenencia La Cruz de Carabineros se llevó detenido a un hombre adulto, luego de que hiciera amenazas de muerte en contra de algunos crucinos.
E l incidente se produjo la noche del jueves pasado, a eso de las 23:00 horas, en la población Santa Rosa de La Cruz. Fue en esos momentos que el hombre habría amenazado con matar a unas personas que residen en este sector de la comuna.
Los vecinos, en medio de su temor y preocupación, pidieron ayuda a los carabineros, los que acudieron al lugar y tomaron detenido al hombre sindicado como el autor de las amenazas. Se trataba de una sujeto de nacionalidad chilena que tiene antecedentes policiales por diferentes delitos. El hombre pasó a control de detención en la mañana del viernes pasado en el Juzgado de Garantía de La Calera.



El ministro de Vivienda, Carlos Montes, junto a autoridades regionales, comunales y más de un centenar de dirigentas y dirigentes sociales de las provincias de San Felipe y Los Andes, durante el Encuentro de Vivienda, Barrio y Ciudad realizado en el Liceo Roberto Humeres.
Más de cien dirigentes sociales del Valle de Aconcagua participaron en la jornada
Con la participación de más de un centenar de dirigentas y dirigentes sociales de las provincias de San Felipe y Los Andes, se realizó en el Liceo Roberto Humeres un encuentro regional convocado por el Ministerio de Vivienda y Urbanismo (Minvu), centrado en el avance del Plan de Emergencia Habitacional. La instancia fue encabezada por el ministro Carlos Montes, junto a autoridades regionales y locales, entre ellas la alcaldesa de San Felipe, Carmen Castillo, y los alcaldes de Los Andes, Santa María, Catemu y Putaendo. También asistieron parlamentarios de la región, como el senador Juan Ignacio Latorre y los diputados Nelson
Venegas, Carolina Marzán y Francisca Bello.
Durante el encuentro, se dialogó sobre el desarrollo de políticas habitacionales y urbanas, además del fortalecimiento del tejido social a través de la participación ciudadana. El ministro Montes destacó que el propósito del encuentro fue “conversar, comprender los problemas desde distintas miradas y fortalecer la democracia construyendo comunidad”. También recalcó que el Minvu debe ir más allá de la construcción de viviendas, integrando el enfoque social y territorial.
A mayo de 2025, el Plan de Emergencia Habitacional registra un 77,2% de avance a nivel nacional, con más de 200 mil viviendas entregadas. En la región de Valparaíso, la cifra alcanza un 67,2%, con más de 21 mil soluciones habitacionales concretadas, incluso en comunas del territorio insular.
La directora (s) del Serviu, Nerina Paz, valoró la retroali-
mentación que generan estas instancias, permitiendo perfeccionar las políticas públicas y reforzar el componente social del plan. Por su parte, dirigentas como Vinka Castro, de San Felipe, y Lucía Díaz, de Panquehue, coincidieron en que estos espacios son fundamentales para expresar necesidades y fortalecer la labor de los comités de vivienda.

El director regional de Corfo Valparaíso, Etienne Choupay, destacó la importancia de seguir apoyando la actividad emprendedora de la región con programas viraliza
Un total de 5 proyectos Viraliza; 3 proyectos Semilla Expande y 2 Programas de Difusión Tecnológica, fueron aprobados por el Subcomité de Innovación y Emprendimiento del Comité Desarrollo Productivo Regional de Valparaíso. Durante la sesión, desarrollada de manera virtual, los consejeros aprobaron la reasignación de fondos al programa Activa Inversión, iniciativa que será corroborado en el próximo Pleno.
El director regional de Corfo Valparaíso, Etienne Choupay, destacó la importancia de seguir apoyando la actividad emprendedora de la región con
programas viraliza, iniciativas que generan sinergia, redes de colaboración y el conocimiento de otras experiencias. “Además de apoyar a los emprendedores, con el programa PDT buscamos promover la incorporación de nuevas tecnologías en nuestras Pymes para hacerlas más competitivas y puedan dar un salto en el crecimiento y desarrollo”.
D urante la sesión realizada a través de la plataforma TEAMS, los consejeros del subcomité de Innovación y Emprendimiento conocieron los proyectos con recomendación de aprobación y rechazo de las

convocatorias Viraliza; Semilla Expande y PDT.
C abe destacar que los programas Viraliza tienen como objetivo fortalecer y mejorar las condiciones de entorno y/o cultura en que se desarrolla la actividad emprendedora e innovadora, validando y promoviendo la opción de emprender y el uso de la innovación como herramientas privilegiadas de desarrollo económico y social, y posicionar a Chile como capital de la innovación y el emprendimiento en Latinoamérica. En ese contexto, se aprobaron por un monto de $245.762.100 de pesos, los siguientes programas: Encuentro Internacional del Ecosistema de Emprendimiento Dinámico e Innovación de la Región de Valparaíso con intervención en San Antonio y Quillota, postulado por la Cámara Regional del Comercio y la Producción, Valparaiso A.G; Valpo Open Hub: Innovación abierta y capital para las industrias que alimentan y movilizan el futuro, postulado por BLUEBOX CHILE SPA; Innovapolinav 2025, postulado por la Academia Politécnica Naval; V21 Open Fest: Innovación que crece desde la región de Valparaíso, proyecto postulado por el Centro de Innovación y Negocios SPA y, 8° Edición del Encuentro de Mercado Musical: VAM - Valparaíso Musical, iniciativa presentada por la Asociación Gremial de la Industria Musical de la Región de Valparaiso-IMUVA.

El sujeto, con antecedentes policiales, fue llevado hasta el hospital local, donde finalmente falleció
L a Brigada de Homicidios de la Policía de Investigaciones se encuentra realizando las diligencias para dar con el paradero de los autores de un homicidio registrado en horas de la noche de este domingo, en el sector de Belloto Sur, en la comuna de Quilpué.
Los hechos habrían ocurrido en el sector de la Villa Italia, donde el hombre de 47 años,
con antecedentes policiales, fue atacado a balazos por desconocidos, que huyeron del sector. El hombre fue llevado hasta el Hospital de Quilpué, donde pese a los esfuerzos médicos por reanimarlo, falleció minutos después en el recinto asistencial; luego de lo cual, pasada la medianoche, se activó el protocolo del Equipo Contra el Crimen Organizado y Homicidios (ECOH) del Ministerio Público, y se constituyó en el lugar el fiscal de turno Osvaldo Basso, quien coordinó las primeras diligencias y entregó detalles de lo ocurrido.
En tanto, el subprefecto Rodrigo Gallardo, jefe de la Brigada de Homicidios Valparaíso, confirmó
que tras concurrir hasta el recinto asistencial junto con el Laboratorio de Criminalística y el médico criminalista para el examen del cuerpo de la víctima, se pudo establecer que ésta “presentaba una herida por proyectil balístico en el tórax anterior”.
Finalmente, la brigada especializada de la policía civil, se trasladó hasta la Villa Italia, en el sector sur de Quilpué, sitio donde ocurrió la balacera, donde están recabando antecedentes con relatos de testigos, análisis de cámaras de seguridad y otros medios, con el fin de establecer la dinámica de lo ocurrido y la identidad de él o los imputados involucrados en este hecho antecedentes que serán proporcionados al Ministerio Público.

Carabineros investiga incidente por un disparo efectuado con un arma artesanal
Este fin de semana se registró una nueva balacera en el distrito de El Melón, la que lamentablemente dejó u na persona lesionada en su tórax producto de u n impacto balístico. A l momento de ejecutarse el disparo, el arma habría presentado u na falla y por eso el proyectil no le dio de lleno a la víctima en el cuerpo.
El i ncidente ocurrió aproximadamente a las 20:00 horas en la vía pública, específicamente en el sector de la plaza El Rungue. Vecinos que estaban cerca de donde se efectuaron los disparos llamaron a Carabineros para alertarles de la situación. Los meloninos además mencionaron que había resultado herida u na persona producto de esta balacera.
Una vez en el lugar, los efectivos policiales realizaron u n patrullaje por los alrededores de la plaza pública. Sin embargo, por más q ue r evisaron, los u niformados no pudieron encontrar a la v íctima. Los policías entonces hicieron averiguaciones con testigos, los que señalaron haber visto que el herido se f ue caminando hacia el Cesfam El Melón.
CARABINEROS
DETENER AL HOMBRE BALEADO PORQUE REALIZÓ AMENAZAS VERBALES AL PERSONAL DE SALUD
Fue a sí q ue los c arabineros del r etén E l Melón s e t rasladaron ha sta d icho c entro de s alud, donde lograron u bicar a l a fectado. S e t rataba de u n h ombre

Pasó a control de detención en el Juzgado de Garantía de La Calera,
adulto, de 4 8 a ños de e dad, que p oseía u n a mplio prontuario p olicial, aunque no tenía n inguna causa penal vigente. Los policías i ntentaron obtener de la víctima más detalles sobre lo acontecido, pero el hombre se negó a realizar la denuncia correspondiente y a entregar a la policía los antecedentes del hecho.
Pocos i nstantes después se vivió u n momento de tensión en el Cesfam El Melón, ya que la víctima adoptó u na actitud violenta m ientras le e staban haciendo las c uraciones de sus heridas y comenzó a amenazar al personal de salud. Carabineros t uvo que controlar esta situación procediendo a detener al afectado.
Observador.cl pudo averiguar en la Tenencia Nogales de Carabineros que las lesiones del hombre serían de carácter leve y que los t iros se habrían percutado con u n arma de fa-
bricación a rtesanal, adaptada para el disparo. Y según la i nformación preliminar, este a rmamento podría haber presentado fallos a l momento de s er accionada.
Aunque la v íctima no quiso denunciar la agresión que sufrió, Carabineros realizó la denuncia de oficio a l Ministerio Público. Hasta el momento no hay personas detenidas por la balacera registrada en El Melón.
Durante el fi n de semana se realizó la audiencia de control de detención del hombre herido, en el Juzgado de Garantía de La Calera, por el delito de amenazas contra los f uncionarios de salud. La Fiscalía informó a Observador.cl que el juez de Garantía consideró que la detención fue legal y s e acordó agendar una audiencia de procedimiento simplificado por este delito. La audiencia quedó fijada para el martes 12 de agosto a las 09:00 de la mañana.
“Ya entregamos más del 50% de los títulos solicitados” dijo el subsecretario de Bienes Nacionales a Radio Observador
En entrevista con Radio Observador, el subsecretario de Bienes Nacionales, Sebastián Vergara Tapia, abordó los principales avances del plan de emergencia desplegado por el Gobierno para regularizar los títulos de dominio de las viviendas afectadas por el mega incendio que azotó diversas comunas de la región en febrero de 2024.
S egún explicó la autoridad, uno de los principales focos ha sido la agilización del trámite de regularización, que tradicionalmente toma un año y medio. Gracias a una modificación en el protocolo de emergencia, este proceso se redujo a solo ocho meses para las familias damnificadas. “Ya hemos entregado más del 50% de las 73 solicitudes recibidas tras el incendio”, señaló Vergara, quien también detalló que fueron gestionadas 609 copias de títulos de dominio para personas que ya contaban con ellos antes del siniestro.
E sta gestión es clave para acceder a subsidios estatales de reconstrucción o autoconstrucción, como los del Serviu, los cuales exigen la tenencia del título de dominio como requisito base. “El título es la puerta de entrada a muchos otros beneficios del Estado”, enfatizó el subsecretario.
Vergara también explicó que, en algunos casos, no ha sido posible avanzar debido a que ciertos terrenos afectados se encuentran en zonas de riesgo, como quebradas o
lechos de río, lo que impide legalmente su regularización. “Aunque duela, el Estado no puede permitir la reconstrucción en zonas que presentan un riesgo evidente para la vida de las personas”, indicó.
O tro de los puntos destacados fue la reciente modificación legislativa que permite regularizar terrenos fiscales de mayor valor –hasta 64 millones de pesos– y en superficies menores a los 5.000 metros cuadrados exigidos previamente para zonas rurales. Estas reformas, según Vergara, facilitarán el acceso a la propiedad a más familias que históricamente no habían podido regularizar su situación.
E n la entrevista, también se abordó el proyecto de ley que busca garantizar
el acceso libre a playas, ríos y lagos, fortaleciendo las facultades de fiscalización y sanción del Ministerio de Bienes Nacionales. La iniciativa contempla multas para quienes obstaculicen el ingreso a estas zonas, las que son bienes nacionales de uso público hasta 80 metros desde la línea de más alta marea o cauce.
Finalmente, el subsecretario reiteró su compromiso con acelerar los procesos de regularización en la región: “Estamos trabajando para que ninguna familia damnificada quede fuera del proceso de reconstrucción por falta de papeles. El Estado debe estar presente con soluciones rápidas y efectivas”, cerró.

La actividad reunió a agrupaciones locales, así como a invitados de otras comunas
Con una gran asistencia de público y un ambiente cargado de tradición y folclore, la comuna de La Cruz celebró por primera vez el Día de la Cuequera y el Cuequero, una jornada especial organizada por las cuatro agrupaciones folclóricas locales, con el apoyo de la Municipalidad.
L a actividad se realizó en la Plaza Comunal y contó con las presentaciones de los conjuntos crucinos “Los Malos Pasos”, “Entre Tacos y Espuelas”, “Raíces de Pocochay” y “Ayún del Aconcagua”, además de agrupaciones invitadas de otras comunas, muestras de campeones y la actuación estelar del grupo emergente santiaguino “Tu Conquista”, que se ha proyectado con fuerza en el circuito cuequero desde su formación en 2024.
M iriam Collado, presidenta
de la agrupación “Los Malos Pasos” y coordinadora de la jornada, destacó el valor simbólico de esta primera conmemoración en La Cruz: “Estamos muy orgullosos de que se pueda hacer aquí en nuestra comuna. Esta es una fecha que nos permite mostrar que la cueca no se vive solo en septiembre. Nosotros la trabajamos todo el año; los niños ensayan, se preparan, y este es nuestro día”, señaló.
La dirigente también valoró el trabajo conjunto entre las
agrupaciones y el respaldo municipal para dar vida a este evento cultural, que esperan replicar en los años venideros: “La idea principal es que esto continúe y se proyecte a través del tiempo. Que se celebre así todos los años”, agregó.
El Día del Cuequero y la Cuequera se conmemora cada 4 de julio a nivel nacional, y en esta ocasión fue celebrado durante el fin de semana siguiente, permitiendo así una mayor participación de la comunidad.


En otro hecho policial, se decomisaron más de 1.800 cajetillas de tabaco de contrabando
En la Ruta 5 Norte, carabineros de la Tenencia de Carreteras de Hijuelas detuvieron al conductor de un camión que no portaba su licencia de conducir, luego de que éste ofreciera $20 mil pesos al personal uniformado, en un intento de dejar sin efecto la amonestación.
Antes de que tratara de sobornar a los policías, los efectivos le informaron al chofer que su falta sería notificada al Juzgado de Policía Local de Nogales. Ante
esto, el chofer intentó evitar ser multado y le ofreció el dinero a los policías, lo que constituyó el delito de cohecho, por lo que fue detenido y puesto a disposición de la Justicia Penal.
En otro hecho que tuvo por escenario la misma autopista, los carabineros de la Tenencia Carreteras de Hijuelas descubrieron un cargamento de cigarrillos ingresados al país de contrabando. En un control rutinario, los policías pudieron encontrar, escondidos dentro de
un automóvil, más de mil 800 cajetillas de tabacos de marcas internacionales.
E l hallazgo ocurrió en el sector del kilómetro 126, cuando los policías hicieron detener un furgón, conducido por una persona mayor de edad, de nacionalidad chilena. El vehículo detuvo su marcha junto a la autopista para hacer la revisión habitual que hacen los carabineros de carreteras en el señalado sector, que se ubica en la bajada de la Cuesta y el Túnel El Melón. Los policías, al efectuar la revisión del móvil, encontraron en la zona habilitada para el transporte de carga un total de mil 880 cajetillas de cigarrillos, ingresados ilegalmente en el país. Su comercialización se encuentra prohibida dentro del territorio nacional, por lo que se tomó detenido al conductor.

Nuevo equipo ecógrafo mejorará la atención ginecológica
A partir de este mes de julio, las mujeres de Hijuelas podrán acceder a ecografías directamente en la comuna, gracias a la incorporación de un moderno ecógrafo de alta gama al Departamento de Salud Municipal.
El anuncio fue realizado por la alcaldesa Verónica Rossat, quien destacó que esta adquisición se concretó gracias a gestiones realizadas con el Servicio de Salud, permitiendo así dar respuesta a una de las necesidades más sentidas de la comunidad.
“El contar con este equipo ecógrafo es una gran noticia para nuestras vecinas, ya que permitirá ofrecer una atención más comple-
ta, cercana y oportuna, sin tener que derivarlas a otras comunas”, señaló la jefa comunal.
El nuevo equipo permitirá realizar cerca de 120 ecografías mensuales, abarcando ecografías obstétricas en todas sus etapas (precoz, primer, segundo y tercer trimestre), así como también ecografías ginecológicas, fortaleciendo la atención integral a las usuarias del sistema de salud municipal.
Gracias a esta incorporación, el Departamento de Salud podrá planificar, ejecutar y entregar resultados directamente en Hijuelas, reduciendo tiempos de espera y evitando traslados innecesarios.
L a matrona Carolina Ramírez, del Departamento de
Salud Municipal, explicó que las ecografías tendrán una duración aproximada de 30 minutos y serán detalladas, permitiendo incluso que las futuras madres puedan ver a sus bebés durante el examen. “Esto mejora considerablemente la experiencia y tranquilidad de las mujeres embarazadas en nuestra comuna”, comentó.
E l ecógrafo ya se encuentra habilitado en el CESFAM Dr. Orlando Orrego, y las ecografías se realizarán entre miércoles y sábado. Desde el Departamento de Salud se recomienda que las mujeres interesadas mantengan sus controles ginecológicos al día para acceder al examen.
Con esta iniciativa, Hijuelas da un nuevo paso en la mejora de su atención primaria, acercando tecnología médica avanzada a sus vecinas y promoviendo una salud más digna, equitativa y eficiente.

Carabineros incautaron más de 10 gramos de droga durante patrullajes preventivos en el centro de la ciudad
Un hombre fue detenido por Carabineros de la Primera Comisaría de Viña del Mar tras ser sorprendido vendiendo droga en las inmediaciones de la Plaza José Francisco Vergara, pleno centro de la ciudad jardín.
D urante una ronda de intervención focalizada en calle Valparaíso y sectores aledaños, los funcionarios policiales ob servaron a un sujeto con acti tud sospechosa. Al proceder a su fiscalización, le encontraron entre sus pertenencias una ba lanza digital, dinero en efectivo y diversas sustancias ilícitas.
E n total, se incautaron 1,5 gramos de fentanilo y más de 9 gramos de clor hidrato de cocaína. Además, parte de la droga se encontraba oculta entre los arbustos de la plaza, lo que evidenciaría que el sujeto utilizaba el espacio público para comercializar
los estupefacientes.
E l mayor Rodrigo Espejo, comisario de la unidad, explicó que “la intervención fue parte de los servicios permanentes que desarrollamos en el centro de Viña del Mar. Gracias a esta fiscalización se logró retirar de circulación
una sustancia altamente peligrosa como el fentanilo”. El detenido, quien contaba con antecedentes por el mismo delito, fue puesto a disposición del Ministerio Público y pasó a control de detención durante esta jornada.
Cabe recordar que, según la DEA (Administración de Control de Drogas de EE. UU.), el fentanilo es un opioide sintético altamente potente, entre 50 y 100 veces más fuerte que la morfina, cuya presencia en las calles representa un grave riesgo para


La agresión se produjo tras una discusión en el tránsito y dejó a la víctima con graves secuelas oculares
E l Juzgado de Garantía de Villa Alemana decretó la prisión preventiva para uno de los imputados por el delito de homicidio frustrado en contra de un conductor del transporte público, quien fue brutalmente agredido tras un altercado vehicular ocurrido en las cercanías del paradero 11 de avenida Valparaíso.
S egún los antecedentes expuestos durante la audiencia de formalización, la agresión ocurrió en los últimos días, luego de una discusión entre los ocupantes de una camioneta y el conductor de un microbús. Los sujetos siguieron al chofer hasta que este descendió del vehículo, momento en el que lo golpearon en el rostro con una manopla y le propinaron diversas patadas.
Debido a la gravedad de sus lesiones, la víctima fue trasladada al Hospital El Salvador, en la Región Metropolitana, donde se le diagnosticó un “gran trauma ocular”, incluyendo una fractura en la órbita

ocular y compromiso visual en su ojo derecho.
Tras las diligencias, dos hombres fueron detenidos y formalizados como coautores del delito de homicidio frustrado. Mientras uno de ellos quedó en prisión preventiva, el segundo imputado quedó sujeto a medidas cautelares de menor intensidad: arraigo nacional y prohibición de acercarse a la víctima.
Durante la audiencia, la jueza Daniela Rodríguez enfatizó la gravedad del ataque, señalando que, aunque pudo existir un conflicto de tránsito previo, “en caso alguno un tipo de esas interacciones puede venir a justificar una agresión de la altura y de la gravedad que se han detallado en este caso”.
L a magistrada agregó que la violencia ejercida fue desproporcionada, considerando que se trató de dos personas jóvenes contra un adulto mayor, y que se utilizaron elementos contundentes en una zona altamente sensible del cuerpo. “Si bien considero que no hay una conducta de dolo directo, sí estimo que puede haber elementos de dolo eventual, porque efectivamente se trata de una zona sensible del cuerpo, y la gravedad de las lesiones puede hacer pensar a cualquier persona que es riesgoso golpear reiteradamente en ese sector”, explicó.


F inalmente, se ordenó el ingreso del imputado al Complejo Penitenciario de Valparaíso y se fijó un plazo de 100 días para la investigación.

La pista se emplazará en Artificio y contempla una inversión de $200 millones
E n una clara apuesta por seguir fortaleciendo la infraestructura deportiva comunal, el municipio de La Calera anunció la construcción de un moderno patinódromo municipal, destinado a entrenamientos y encuentros de alta competencia en patinaje en línea.
El proyecto, que será ejecutado en 2026, se ubicará en el sector de Artificio, a un costado del Estadio Municipal de Pueblo Nuevo, en un terreno que por años estuvo en desuso y que ahora será transformado en un espacio de primer nivel para los amantes de esta disciplina.
E l alcalde de La Calera, Johnny Piraino, destacó que esta iniciativa representa un nuevo paso en la consolidación del polo deportivo comunal: “Nos encontramos en un terreno que estuvo abandonado durante años y que hoy hemos recuperado para levantar una nueva infraestructura deportiva: un patinódromo que complementará al Estadio de Pueblo Nuevo, ampliando la oferta deportiva para niños, niñas, jóvenes y adultos que practican patinaje en línea en nuestra ciudad”, señaló la autoridad comunal.
DEL PATINÓDROMO
L a obra contempla la cons -


Permitirá a deportistas locales entrenar en un espacio especialmente
trucción de una pista de patinaje de 200 metros de longitud, distribuida en seis carriles, con una superficie total aproximada de 2.403 metros cuadrados. El diseño incluye además una pista educativa, un reductor de velocidad, un andén de circulación y una baranda perimetral para garantizar la seguridad de todos los usuarios, especialmente de niños y deportistas en formación.
La pista será construida en hormigón pulido y contará con pintura acrílica, materiales que aseguran durabilidad y un óptimo
rendimiento para la práctica del patinaje competitivo. Además, se instalará un moderno sistema de iluminación, con luminarias centrales y focos específicos en el sector de partida, permitiendo su uso en horarios nocturnos sin comprometer la visibilidad ni la seguridad.
La inversión total del proyecto asciende a $200 millones, financiados a través del Fondo Regional de Iniciativa Local (FRIL), y forma parte del compromiso del Gobierno Comunal por fomentar el deporte en todas sus expresiones.



Declaración Pública

Federación de Medios de Comunicación Social

Ante el reciente proyecto de ley conocido públicamente como “Ley Mordaza 2.0” impulsado por un grupo de senadores que busca sancionar la filtración y difusión de información en causas judiciales declaradas reservadas, desde la Federación de Medios de Comunicación Social manifestamos nuestra profunda preocupación por el grave precedente que esta iniciativa podría sentar para el ejercicio libre del periodismo en Chile.
Declaración Pública
Federación de Medios de Comunicación Social
Ante el reciente proyecto de ley conocido públicamente como “Ley Mordaza 2.0” impulsado por un grupo de senadores que busca sancionar la filtración y difusión de información en causas judiciales declaradas reservadas, desde la Federación de Medios de Comunicación Social manifestamos nuestra profunda preocupación por el grave precedente que esta iniciativa podría sentar para el ejercicio libre del periodismo en Chile.
Creemos que este proyecto pone en serio riesgo la libertad de prensa y el derecho ciudadano a estar informado, pilares fundamentales de una democracia sana y transparente. La historia reciente de nuestro país ha demostrado que muchos de los casos de corrupción, violaciones a los derechos humanos o abusos de poder se han destapado gracias a investigaciones periodísticas. Criminalizar el trabajo de periodistas que cumplen con su deber de informar no solo representa un retroceso democrático, sino que instala un mensaje de amedrentamiento que atenta contra el rol fiscalizador de los medios y la labor informativa que se ejerce.
Creemos que este proyecto pone en serio riesgo la libertad de prensa y el derecho ciudadano a estar informado, pilares fundamentales de una democracia sana y transparente. La historia reciente de nuestro país ha demostrado que muchos de los casos de corrupción, violaciones a los derechos humanos o abusos de poder se han destapado gracias a investigaciones periodísticas. Criminalizar el trabajo de periodistas que cumplen con su deber de informar no solo representa un retroceso democrático, sino que instala un mensaje de amedrentamiento que atenta contra el rol fiscalizador de los medios y la labor informativa que se ejerce.
En una democracia sólida, el periodismo no debe ser perseguido ni limitado por medidas legales que puedan abrir espacio a la censura o al autocontrol forzado. Más aún cuando las instituciones deben ser las responsables de contar herramientas para sancionar filtraciones indebidas dentro del aparato estatal, sin necesidad de trasladar esa responsabilidad al ámbito periodístico.
En una democracia sólida, el periodismo no debe ser perseguido ni limitado por medidas legales que puedan abrir espacio a la censura o al autocontrol forzado. Más aún cuando las instituciones deben ser las responsables de contar herramientas para sancionar filtraciones indebidas dentro del aparato estatal, sin necesidad de trasladar esa responsabilidad al ámbito periodístico.
Como Federación, rechazamos cualquier intento por restringir el derecho a informar y a ser informado. Reiteramos nuestro llamado a las autoridades a proteger y fomentar un ecosistema informativo libre, diverso y sin presiones indebidas.
Como Federación, rechazamos cualquier intento por restringir el derecho a informar y a ser informado. Reiteramos nuestro llamado a las autoridades a proteger y fomentar un ecosistema informativo libre, diverso y sin presiones indebidas.
12 de junio de 2025
12 de junio de 2025







Eugenio Fierro Preparador físico y conferencista del equipo High Fitness
En lugar de trepar árboles, caerse o ensuciarse en el parque, muchos niños pasan horas frente a pantallas, donde los verdaderos riesgos invisibles e intangibles se desarrollan en silencio.
L as preocupaciones de padres y cuidadores son comprensibles. Nadie quiere ver a un hijo lastimarse o correr peligro. Sin embargo, como plantea el psicólogo social Jonathan Haidt en su libro Generación Ansiosa, proteger en exceso a los niños de los riesgos físicos propios del juego libre puede ser más dañino que beneficioso.
La clave de este argumento radica en un concepto poderoso: la antifragilidad. A diferencia de algo frágil, que se rompe con el estrés, lo antifrágil se fortalece al enfrentarlo. El cuerpo humano, el sistema inmune y también el carácter de un niño funcionan así: necesitan pequeñas dosis de incertidumbre, riesgo y desafío para desarrollarse plenamente.
H aidt recupera investigaciones como las de los noruegos Ellen Sandseter y Leif Kennair, quienes concluyen que “las experiencias emocionantes tienen efectos antifóbicos”. Es decir, los niños vencen sus miedos enfrentándolos, no evitándolos. Cuando un niño trepa una estructura alta en el parque o intenta deslizarse por una pendiente más empinada con su pa -

tineta, está desafiando sus propios límites. Lo hace porque su cuerpo y mente le piden crecer.
Este tipo de juego, que puede parecer imprudente a ojos adultos, es en realidad una etapa esencial del desarrollo emocional, cognitivo y motor. Y, sin embargo, muchas veces es interrumpido por advertencias como “¡bájate de ahí!” o “¡te vas a caer!”. Paradójicamente, esos mismos niños pueden volver a casa y pasar horas navegando en redes sociales sin supervisión, donde enfrentan amenazas más serias y difíciles de detectar: comparaciones constantes, ciberacoso, exposición a contenidos nocivos y una vida digital que condiciona su autoestima.
¿Estamos mirando al lugar equivocado? ¿Estamos más preocupados por una rodilla raspada que por un algoritmo que les dice cómo deberían verse o comportarse?
No se trata de abandonar los cuidados, sino de replantear qué entendemos por protección real. Tal vez proteger sea también permitir. Permitir que se equivoquen, que se caigan, que aprendan. Que vivan el mundo físico con todas sus texturas y desafíos.
E n definitiva, los niños no necesitan entornos libres de riesgos, sino entornos seguros para asumirlos. Y eso, más que limitar, implica acompañar.
“Nunca, o casi nunca, toca coincidir con un hecho que marca la historia de un país. Pienso en ese día y me sale la palabra imposible. Quizás, me lleve toda una vida comprender lo que pasó. Siento que el fútbol siempre es fútbol, pero ahí había algo más. Algo que incluso me escapaba como entrenador. O me atravesó. Porque el hecho es que la búsqueda de un título acompañó a un país a saber que, más allá de las dificultades o las diferencias, la unidad puede romper cualquier barrera”
Jorge Sampaoli, ex entrenador de la “Roja” (cooperativa.cl, 4 de julio 2025)
EMPRESA PERIODÍSTICA EL OBSERVADOR
“La Verdad más que un valor es una actitud ante la vida”
Roberto Silva Bijit
Fundador y Presidente del Directorio:
Roberto Silva Bijit
Director:
Roberto Silva Binvignat
Jefe de Informaciones: Gabriel Abarca Armijo
La Concepción 277 - Quillota www.observador.cl
PUBLICIDAD
Coordinadora Comercial:
Verónica Tapia Herrera ventasquillota@observador.cl Fono: +56 9 8887 9747Casa Matriz - Quillota

¿Y si el problema no es la discapacidad, sino el entorno?
Cuando pensamos en el medio ambiente, solemos imaginar naturaleza, reciclaje o cambio climático. Pero pocas veces nos detenemos a analizar cómo el entorno urbano o rural afecta directamente a quienes viven con alguna discapacidad. Veredas rotas, ruido excesivo, falta de señalética o espacios sin accesibilidad no son detalles menores: son barreras que muchas personas enfrentan cada día, y que limitan su autonomía y participación. Hoy, desde nuevas miradas sobre la discapacidad, entendemos que el problema no está en la persona, sino en cómo el entorno responde (o no) a sus necesidades. Esta idea nos
invita a pensar distinto, especialmente en las escuelas. Docentes de aula regular y de educación diferencial tenemos la oportunidad y la responsabilidad de crear espacios más accesibles, amables y conscientes de esta diversidad humana. No se trata solo de adaptar actividades o materiales, sino de observar el entorno completo: ¿es acogedor?, ¿permite participar?, ¿incluye de verdad? Ahí está el verdadero desafío. Porque si cambiamos la forma en que diseñamos y habitamos los espacios educativos, también estamos cambiando la forma en que valoramos la presencia y el derecho de todos y todas a estar, aprender y construir comunidad.
Jessica Durán Académica Pedagogía en Educación Diferencial UDLA
“Es una señal preocupante”
Carla Morales Diputada RN
“El Presidente Boric insiste en actuar más como jefe de campaña del oficialismo que como Jefe de Estado. Su participación en un acto del Partido Socialista, donde hizo un llamado explícito a la unidad de la izquierda y a levantar una lista única parlamentaria, es una señal preocupante de lo que viene, donde tirarán la casa por la ventana”
(EMOL, 4 de julio 2025)

“Sabemos cuál es la ley”
Aisén Etcheverry Vocera de Gobierno
“Una cosa es la posición política que tiene el Ejecutivo, que es conocida por todos y que está representada en los partidos de la coalición, que esperamos que crezca y que convoque a muchos más. Pero otra cosa distinta es que todas las autoridades sabemos cuál es la ley en materia de prescindencia política (…) por lo que (la normativa) se va a respetar siempre”
(cooperativa.cl, 4 de julio 2025)
El viernes, se cumplieron 10 años del día que la Selección Chilena logró coronarse campeón de la Copa América por primera vez en la historia del fútbol chileno. El sábado 4 de julio de 2015, La Roja enfrentó a Argentina en la final del torneo que se organizó en nuestro país y que permitió poner fin a cien años de desilusiones.
Esa tarde noche, ante un Estadio Nacional repleto, el combinado nacional hizo historia, premio a una gran generación de jugadores. A nadie en el país dejó indiferente el título conseguido. Desde Ñuñoa, y luego del dramático triunfo mediante lanzamientos penales sobre la Argentina de Lionel Messi, se irradió una ola de alegría y emoción por todo Chile.
El penal ejecutado por Alexis Sánchez, quizás el principal representante de una generación nueva de futbolistas ganadores, provocó un desahogo generalizado y una marea de felicidad contenida por décadas.
Pasan los años y ahora una década, y esa noche y ese título conseguido adquiere mayor sentido e importancia. Más aún hoy en
día, cuando la realidad de la Selección Chilena y el fútbol de nuestro país, es diametralmente opuesta. Si hace 10 años se celebraba por ser los mejores de América, en la actualidad miramos a todos desde el sótano del Continente.
E l recuerdo de lo sucedido hace 10 años, también adquiere importancia para la Provincia de Quillota, ya que hubo participación directa en esa recordada final con Argentina y en la campaña en general.
Un año antes Matías Fernández, el calerano, el Mejor de América en 2006, no pudo estar en el Mundial de Brasil. Una lesión le impidió al “Mati” ser parte del gran campeonato de La Roja. El destino le tenía deparado otra cosa al entonces jugador de la Fiorentina de Italia.
E n la Copa América de 2015 la presencia de Matías Fernández fue fundamental, sobre todo en la final con los trasandinos. Luego del empate sin goles en los 120 minutos de partido, vino la definición por penales, una instancia cargada de nerviosismo y tensión, en la cancha, en las tribunas y en los hogares de
millones de chilenos. S olo años después se supo de la trastienda del famoso primer penal. Era Arturo Vidal quien iba a patear el primer penal de la tanda para Chile. Sin embargo, Matías Fernández decidió ser el primero. “Yo quiero ir primero, Arturo”, le dijo el calerano al actual jugador de Colo Colo. “¿De verdad, Charrito?”, preguntó Vidal. “Sí, déjame a mí”, respondió Fernández.
Lo que vino después fue, como ha sido considerado desde entonces, el “Penal Perfecto”. Un potente derechazo que se hizo inatajable para Sergio “Chiquito” Romero, el arquero de Argentina. El año pasado, con motivo de su despedida oficial del fútbol, Matías Fernández comentó sobre ese famoso penal y explicó que “le dije a él (Arturo Vidal) y al profe (Sampaoli) que yo quería empezar, no sé si para salir luego del tema o me tenía mucha fe” y agregó que “cuando tomé la pelota sabía a qué lado la quería poner, apunté a la derecha del arquero, pero mi remate si bien iba donde quería, subió más de lo que pensaba. Nunca tuve la inten-

El 4 de julio se cumplió una década desde el primer título de la roja.
ción de que se elevara así”.
E se penal trazó el camino y le dio mucha más confianza a La Roja, y a Arturo Vidal, Charles Aránguiz y Alexis Sánchez, los pateadores que siguieron a Matías y que no fallaron esa noche de julio.
E sa noche, pese a su conocido estilo reservado y de pocas palabras ante la prensa, Matías Fernández, no se guardó nada en la celebración. El “Mati” fue entrevistado por la televisión luego de los festejos y al ser consultado por su sensación de ser campeón de América junto a su compañero en la Fiorentina, David Pizarro, el calerano comentó: “es una instancia muy bonita, me siento orgulloso de haber ganado la copa junto a él y más si es defendiendo a tu país. Agradezco a Dios porque soy cristiano”.
La respuesta de Fernández sorprendió a Pizarro, quien aprovechó de bromear con el mediocampista. “Es primera vez que te escucho, Mati”, le dijo el porteño en el enlace televisivo, a lo que Fernández respondió: “es una situación especial.
Es imposible no hablar”.
El quillotano Francisco Silva no estaba nominado para la Copa América de 2015. Jorge Sampaoli se había decidido por otro volante. Sin embargo, la lesión del iquiqueño Edson Puch solo días antes del inicio del torneo continental, le abrió la puerta a último momento al “Gato”.
Es curioso e increíble lo de Silva, ya que en toda la Copa América no sumó ni un solo minuto antes de la final con Argentina. Pese a ello, el DT de La Roja no dudó en decidirse por él para reemplazar a Gonzalo Jara para la gran final.
Francisco Silva era un jugador importante para Sampaoli y eso quedó demostrado un año antes, cuando en el Mundial de Brasil, el quillotano –formado futbolísticamente en Universidad Católica- fue titular en casi todos los partidos de La Roja.
El volante quillotano no desentonó en la final de Copa América y de hecho fue uno de los destacados esa tarde frente a Argentina, en un
puesto que no era el suyo y marcando a jugadores destacados. Jugó los 120 minutos y como sus compañeros, festejó el primer título internacional de nuestro fútbol.
El destacado futbolista quillotano se inició en el Club La Tetera y también se le recuerda correr tras una pelota en la Ex Escuela 4, hoy Escuela Arauco, sin imaginar nunca que su nombre estaría vinculado a los más grandes logros futbolísticos de la Selección Nacional.
Si el trabajo del “Gato” Silva fue importante en la final frente a Argentina en 2015, un año después, el destino le tenía deparado un papel protagónico, con el recordado penal también ante los trasandinos, en la final de la Copa América Centenario en Estados Unidos, donde Chile obtuvo el bicampeonato continental.
A lo largo de toda la Copa Amé-

El penal perfecto de Matías Fernández que abrió el camino.
rica 2015, el ex dirigente calerano Sergio Jadue estuvo presente en cada uno de los juegos de la selección, en su calidad de presidente del fútbol chileno, pero también con la pasión de un hincha. Así quedó reflejado por ejemplo con el efusivo festejo en la victoria sobre Uruguay en los cuartos de final y también en la jornada final ante Argentina, donde se abrazó y festejó junto a los jugadores nacionales en la cancha del Coliseo de Ñuñoa para posteriormente entregar las medallas a los argentinos y a los propios chilenos, además de entregar la copa a los campeones. Esa noche aseguró la continuidad de Jorge Sampaoli como técnico de La Roja y además prometió que la Copa América recorrería todo el territorio nacional. Nadie imaginaba esa noche de julio, que meses después, Jadue abandonaría en silencio el país para llegar a Estados Unidos como testigo protegido del FBI, como parte de la investigación de la Justicia norteamericana del Caso FIFA Gate. Acusado y confeso por los casos de sobornos en el fútbol, Sergio Jadue espera su condena en Estados Unidos, y en los últimos meses ha
reaparecido públicamente, debido a una entrevista y su presencia en redes sociales.
De hecho, este viernes en su cuenta de X, el ex dirigente calerano posteó recordando el título de 2015. “Gracias a la vida por haber sido parte del mayor y más recordado
éxito futbolístico de nuestro país. La noche del 4 de julio de 2015, hace 10 años, 18 millones de chilenos fuimos uno solo…y todos fuimos Campeones de América”, expresó Jadue junto a un video de los momentos claves de esa Selección Chilena.


Recuerdos de la histórica noche del 4 de julio.

¿Logró llegar a la cumbre del Tupungato?
El complejo momento de salud de Pangal Andrade en ‘El Clan’
La noche del sábado, en un nuevo episodio de El Clan, Pangal Andrade y sus primos fueron a hacer cumbre de los volcanes Tupungato y Tupungatito, en el límite con Mendoza, Argentina
Sin embargo, la aventura no estuvo exenta de problemas para el triunfador de Ganar o Servir. El equipo se preparó para este desafío, ya que los volcanes tienen una altura que superan los 6.600 y 5.600 metros sobre el nivel del mar, por lo que no es fácil conseguir el hito.
En el camino, llegaron al gran refugio “Tupungato”, donde pudieron almorzar, pero al seguir el camino, varios miembros del clan comenzaron a marearse y tener dolores de cabeza debido a la falta de oxígeno.
Como si eso no f uera suficiente, el grupo se atrasó, ya que Andrade tomó la mala decisión de irse por otro camino, lo que molestó al guía de la ruta.
S in embargo, Pangal logró hallar el camino y se reunió con los demás, pidiendo las disculpas
correspondientes.
D entro de las últimas jornadas, Pangal sufrió el mal de altura, con dolores de cabeza, de cuerpo e incluso vómito.
‘’Quién me manda a hacer programas en alturas de la cordillera. No puedo respirar, me duele la cabeza, me duelen las piernas. Me las doy de andinista adónde la vi’’, expresó Pangal.
Es por eso que decidió bajar al refugio junto a su hermano Lorenzo, y en la noche decidieron que subirían a la cumbre del Tupungatito.
Finalmente, subieron nuevamente y después de 11 horas caminando, lograron llegar a la cumbre de dicho volcán junto a
sus primos, pero solamente Sebastián Andrade logró llegar a la cima del Tupungato.


Aseguran que rostro principal de ‘Mundos Opuestos’ se está separando tras más de 10 años de relación
Este fin de semana, Cecilia Gutiérrez sorprendió en redes sociales al revelar que un rostro principal del reality Mundos Opuestos estaría atravesando una separación
Hablamos de Karla Constant, conductora del programa de Canal 13 que por estos días se graba en Perú, tal como sus tres antecesores: Tierra Brava, Ganar o Servir y Palabra de Honor.
Todo partió con una ronda de preguntas y respuestas que hizo la periodista en sus historias de Instagram, justo antes de salir de vacaciones.
“¿La Karlita Constant sigue con su marido?”, quiso saber uno de los seguidores de la panelista de Primer Plano. ”Están en proceso de separación”, respondió ella escuetamente.
ANIMADORA DE MUNDOS OPUESTOS ESTARÍA VIVIENDO CRISIS EN SU RELACIÓN
Recordemos que la conductora está en pareja con el publicista Andrés Vilaseca desde hace más de 10 años, y juntos son padres de Rocco.
Andrés es un coach en International Business & Life y se graduó con honores del programa Master Coach Core Competencies, con una certificación del estado de California de Estados Unidos.
E n una entrevista anterior al

estreno de Mundos Opuestos, Karla Constant comentó a Página 7 que había logrado, hasta ahora, sortear bien el tema de la distancia con su familia por el trabajo, sobre todo con sus hijos, Pedro y Rocco:
“Les da la oportu nidad de descu brir que tienen un papá, que pueden resolver cosas con él, que tienen una propia dinámica, y no pasa nada. Solo pueden salir cosas buenas de eso”, aseguró en esa oportunidad.
S in embargo, las fuentes de Ce cilia Gutiérrez -que nunca se equivo can- apuntan a una crisis que estaría distanciando a Karla Constant de su pareja.



Este viernes 4 de julio se realizó en el Centro de Eventos Dejando Huella, en Limache, el punto de prensa oficial del concurso gastronómico “Rescatando Sabores del Ayer”, una iniciativa que busca relevar la cocina tradicional de las personas mayores de la Región de Valparaíso y rescatar recetas cargadas de historia, identidad y memoria familiar.
La actividad reunió a organizadores, chef e integrantes de la tercera edad, entre ellos, representantes del centro de eventos, encabezados por Gerald Havliczek, y la directora de carreras de Gastronomía de Duoc UC Sede Valparaíso, Soledad Venegas, quienes destacaron el valor cultural y humano de esta convocatoria.
La iniciativa que busca la participación de los adultos mayores de la región es organizada por el Centro de Eventos Dejando Huella con el apoyo de la Escuela de Gastronomía de Duoc UC Sede Valparaíso.


Desde Duoc UC Sede Valparaíso, institución que forma parte del jurado y apoyo técnico del concurso, la directora de carreras de Gastronomía señaló que: “Para nuestros docentes y estudiantes es una oportunidad única de aprender de la expe riencia viva de quienes han cul tivado la cocina chilena desde sus hogares y barrios. Es un rescate con sentido”, comentó. Por su parte, el representante del Centro de Eventos Dejando Huella invitó a toda la comu nidad regional a participar: “Queremos que este concurso sea una fiesta de la memoria culinaria. Abrimos este espacio para escuchar, saborear y emocionarnos con los platos que han acompañado generaciones y que esperamos mantener vivos en las cocinas de nuestro centro de eventos de Limache, Olmué y Valparaíso”, sostuvo. El concurso está abierto a personas mayores de 50 años, no profesionales, que re



sidan en cualquier comuna de la Región de Valparaíso. Las bases completas y formulario de inscripción están disponibles en el siguiente enlace: https://dejan-
dohuella.cl/rescatando-sabores-del-ayer/ Finalmente, la señora María Elena Jara, integrante de la tercera edad presente en la actividad, concluyó que: “este concurso permitirá recordar a nuestros
padres, abuelos y bisabuelos que cocinaban tan rico, a veces con tan poquitas cosas; como olvidar esas papitas con chuchoca y chicharrones, las prietas que las rellenaban con nueces, las humitas, tanta cosa rica”.

Jurado evalúa propuestas alimentarias con criterios de innovación, salud y sostenibilidad.

Esfuerzo, dedicación y compromiso son los ingredientes que han definido los proyectos que año a año se presentan en la ExpoFeria de Alimentos Innovadores. A la fecha perduran en los visitantes de esta feria e integrantes de la Facultad de Ciencias Químicas y Farmacéuticas de la U. de Chile alguna imagen o recuerdo sobre las novedosas propuestas que han nacido en los laboratorios y salas de clases de la carrera de Ingeniería en Alimentos.
Una larga fila esperaba expectante el inicio de esta verdadera fiesta el pasado jueves 3 de julio. Pasadas las 14 horas el decano Pablo Richter brindó su discurso inaugural. “Este evento es un gran proyecto de la facultad, que forma parte de la carrera de Ingeniería en Alimentos y fue concebido y mate-
Este año ganaron tres proyectos creados por mujeres, entre ellos “Kefrut”, queso crema probiótico; “IceBeans”, helado proteico en base a porotos rojos, y “Gamaki”, nugget a base de quinoa y garbanzos.

Con corte de cinta se dio apertura a una nueva versión de la ExpoFeria. La ceremonia contó con la participación de autoridades, docentes y estudiantes de Ingeniería en Alimentos.
Autoridades académicas y representantes de
a los

Viene de página anterior
rializado por la profesora Lilian Abugoch James, se ha consolidado como una de las tradiciones más representativas de nuestra facultad”, sostuvo.
“Nació en los pasillos de Vicuña Mackenna 20, y hoy es una de las principales exposiciones de su tipo en nuestra universidad, que moviliza a toda la comunidad universitaria alrededor de los trabajos de los futuros ingenieros en Alimentos. En cada edición, la innovación en los desarrollos presentados se armoniza cuidadosamente con los principios de una composición saludable y, por supuesto, con la sostenibilidad ambiental en cada uno de los procesos”, agregó.
Esta tradición nació en el contexto de la asignatura Ingeniería en Procesos de Conservación de Alimentos, liderada por la profesora Lilian Abugoch, académica del Departamento de Ciencia de los Alimentos y Tecnología Química. Con el tiempo también se sumó el profesor Claudio Inostroza, a través del curso Evalua-
ción de Proyectos y la profesora Loreto Contador, en Evaluación Sensorial. Tres áreas que permiten a los estudiantes poder abordar de una manera integral los diversos ejes al momento de construir sus proyectos.
En esta versión, el desafío fue mucho mayor, ya que los proyectos fueron de carácter individual y nacidos bajo el lema de este año: “El Sabor de Un Mundo Mejor”. Sin embargo, los estudiantes recibieron el apoyo de sus compañeros y amigos en la presentación de sus productos:
“Dulce Ciclo”: galleta de formato de 40 gramos, cuya forma es circular con forma de domo. Este galletón posee el sabor a cacao y a naranja, sabores obtenidos gracias a la combinación del cacao amargo en polvo y del polvo de cáscara de naranja, añadiendo más ingredientes, como las harinas de maíz y de avena, margarina y huevo, para darle forma y textura a la galleta final.
“Gummy Planet”: son gomitas de dinosaurio sin azúcar, con dos tipos de sabores: naranja y uva, estos son dados por la harina de cáscara de naranja y harina de bagazo de uva.
“Son unas gomitas hechas a base de harina, cáscara de naranja y bagazo de uva, con el fin de entregar unas gomitas saludables a los niños, que son los que más consumen dulces. Son una buena fuente de fibra y vitamina C”, sostiene Paulina Monárdez Dellacasa.
“Gamaki”: es un innovador nugget con forma de conchita de mar, con un exquisito sabor marino, relleno suave y cremoso, y una cobertura crocante de quinoa. Está elaborado a base de quinoa y garbanzos, lo que lo convierte en una buena fuente de proteína vegetal. Es un producto completamente vegano, libre de sellos, soya y gluten, pensado para todo tipo de público.
“Gamaki es un nugget vegano con un sabor marino
“IceBeans”, helado proteico a base de porotos rojos, ganó el premio del público. La propuesta de Javiera Rozas fue valorada por su sabor, innovación y aporte nutricional.

para distinguirlo de muchos otros productos veganos que están en el mercado. Está hecho de garbanzo y de quinoa, siendo una buena fuente de proteína”, explica María José Romero.
“IceBeans”: es un helado con una buena fuente de proteína, libre de sellos, con una excelente fuente de fibra prebiótica que ayuda a la digestión y provoca saciedad, además de ser bajo en grasas saturadas y sodio lo que promueve la salud cardiovascular.
“Es un helado de proteína a base de porotos rojos. Es una excelente fuente de fibra prebiótica, ya que contiene inulina. Es bajo en grasas saturadas”, cuenta Javiera Rozas Ibáñez.
“CERVEG”: es un embutido vegetal tipo salchichón cervecero, desarrollado a partir de una formulación innovadora que incorpora champiñones, proteína vegetal (arroz y arveja), chuño, harina de arroz y una mezcla de condimentos naturales. Está diseñado como una alternativa
saludable, sostenible y sabrosa, orientada a consumidores flexitarianos, vegetarianos y veganos.
“Es un salchichón cervecero vegetal que nace con la idea de hacer un embutido vegetal libre de gluten y de alérgenos. Los que hay en el mercado la mayoría posee proteína de soya o harina de trigo, la idea era desmarcarnos de eso”, dice Emilio Valdivia.
“Kale & Krunch”: snack horneado tipo chips, crujiente y saludable hecho con kale, camote, entre otros, 100% vegetal, libre de gluten y perfecto para picar entre comidas. Apto para personas celíacas, veganas y con requerimientos de alimentación saludable.
“Mi idea es vender un producto sano y rico, libre de sellos y gluten, apto para celiacos, veganos y vegetarianos, con ingredientes naturales, bajo en grasas, sin aditivos y conservantes. Es horneado”, describe Emilia Valenzuela Lara.
“Kefrut”: un queso crema
probiótico elaborado a base de leche entera fermentada con gránulos de kéfir. Enriquecido con inulina, un prebiótico natural que favorece la digestión, y tagatosa, un endulzante saludable de bajo índice glicémico. Además de contener pulpa de frutillas, la cual otorga matices frescos y frutales. Es libre de sellos, libre de gluten y libre de soya.
“Fue una experiencia inolvidable, un trabajo duro, pensar en un producto innovador que le puede gustar a las personas. Me siento conforme. Va dirigido a las personas que tienen problemas digestivos”, señaló María Paz Vásquez Rivas.
Al inicio de la ceremonia se rindió un homenaje a Jorge Guzmán de HELA por su constante apoyo a esta iniciativa, a quien se le obsequió un galvano. Hasta que llegó la hora esperada de conocer los resultados de la ceremonia. El nerviosismo se apoderaba de los presentes. Primero se anunció al ganador de la votación popular fue el proyecto IceBeans, que obtuvo la mayoría de las preferencias del público, a través del escaneo de un código QR ubicado en los stands. El diploma fue entregado por Nicolás Retamal, estudiante de Ingeniería en Alimentos y representante del Centro de Estudiantes de la carrera. El tercer lugar lo obtuvo María José Romero, con su propuesta Gamaki. El diploma fue entregado por la presidenta del Jurado profesora Nalda Romero.
“Muy inesperado. De verdad que no me lo esperaba, así que estoy bastante contenta. El

premio es increíble, el hecho de poder cursar un diplomado gratuito, maravilloso. Dar las gracias, a mis amigas que estuvieron aquí todo el rato conmigo. Fue mucho trabajo al ser individual, pero valió la pena el esfuerzo”, sostuvo Romero.
El segundo lugar también fue para Javiera Rozas Ibáñez con su proyecto IceBeans. El diploma fue entregado por la vicedecana (s) profesora Paz Robert.
“Estaba demasiado nerviosa. Yo quería ganar, siento que trabajé harto, que todo este proyecto conlleva un trabajo enorme detrás y esta vez que estábamos solos fue mucho más, la presión fue súper grande, pero valió totalmente la pena. Así que estoy muy contenta, relajada. Me siento contenta de que a la gente le haya gustado”, manifestó Rozas.
El primer lugar recayó en Kefrut de María Paz Vásquez. El diploma fue entregado por el decano profesor Pablo Richter.
“Estoy demasiado emociona-
da, nerviosa y muy feliz, porque fue harto trabajo durante mucho tiempo. Es un logro, un desafío, así que estoy muy contenta por el logro. Lo esperaba, pero mis compañeros tenían también muchos productos muy buenos, entonces era muy impredecible lo que podía pasar”, enfatizó Vásquez.
Todos los ganadores recibieron una beca para cursar cualquier diploma que imparta la Facultad, las que fueron entregadas por el profesora Harold Mix, subdirector de Educación Continua. Asimismo, las empresas Cramer, IANSA, HELA y Puratos también entregaron regalos a los ganadores.

La actividad reunió a la comunidad en torno a proyectos individuales creados bajo el lema “El sabor de un mundo mejor”.

Un innovador proyecto que utiliza modelos matemáticos tradicionales junto a técnicas de Inteligencia Artificial (IA), especialmente aprendizaje automático, para mejorar la productividad en el cultivo de microalgas, está desarrollando el académico de la Escuela de Ingeniería Bioquímica de la Pontificia Universidad Católica de Valparaíso (PUCV), Carlos Martínez.
Se trata de “Mejora de modelos dinámicos de sistemas de cultivo de microalgas con aprendizaje autónomo”, un proyecto Fondecyt de Iniciación que tiene como principal objetivo la digitalización de los bioprocesos, es decir, establecer modelos matemáticos de microalgas que
Sigue en página siguiente
Proyecto de la PUCV apunta a optimizar el cultivo de estos microorganismos utilizados para elaborar alimentos, fármacos, cosméticos y para purificar aguas residuales, entre otros usos.


tengan alta fidelidad y puedan representar de manera muy precisa su crecimiento.
“La idea es que el computador pueda tomar decisiones en base al estado del cultivo, gracias al modelo matemático que le vamos a introducir. La principal innovación tiene relación con el hecho de combinar modelación matemática clásica con métodos de aprendizaje automático”, explicó Carlos Martínez.
A través del análisis de la información obtenida por sensores que miden el oxígeno disuelto, el dióxido de carbono, la temperatura, el PH y la intensidad luminosa –entre otras variables–, el modelo matemático podrá predecir los distintos escenarios de lo que podría ocurrir con los cultivos de microalgas, facilitando la toma de decisiones para controlar el buen estado de la productividad dentro del reactor.
“Esta tecnología es útil para
cualquier industria que se interese en la producción de microalgas. Éstas tienen muchos usos y aplicaciones, por ejemplo, en la elaboración de alimentos tanto para humanos como para animales; de hecho, no es extraño encontrar en una farmacia suplementos alimenticios a base de microalgas como clorella
vulgaris o spirulina; también se utilizan en la producción de cosméticos y de biocombustibles donde tal vez no han tenido tanto éxito pero es debido a la baja productividad. Justamente contar con modelos matemáticos precisos nos podría ayudar

a diseñar estrategias de cultivo que puedan aumentar la productividad”, detalló Martínez, quien además es académico del doctorado en Ingeniería Bioquímica de la PUCV.

Esta iniciativa apunta a la digitalización de los bioprocesos, palabra clave que tiene que ver con la Inteligencia Artificial y la industria del 4.0 –también conocida como la Cuarta Revolución Industrial– que se refiere a la integración de tecnologías digitales inteligentes en los procesos industriales y de fabricación. La industria del 4.0 implica la interconexión de dispositivos, la automatización, el análisis de grandes cantidades de datos y la Inteligencia Artificial para crear fábricas inteligentes y cadenas de suministro más eficientes. En este contexto, el proyecto Fondecyt que lidera el académico de la PUCV pretende hacer modelos matemáticos que puedan representar de manera
muy precisa el crecimiento de microalgas, pensando en un futuro exportarlos a la industria para poder aportar en la digitalización de los bioprocesos.
“Estas técnicas de modelación híbrida que combinan modelos clásicos con aprendizaje automático sirven para cualquier bioproceso. Durante esta investigación vamos a implementarlas en microalgas, pero la idea es extrapolar a otros bioprocesos. De hecho, nos acabamos de adjudicar un proyecto interdisciplinario interno de la PUCV en el que vamos a usar técnicas de modelación similares, pero en levaduras para la producción de proteínas recombinantes”, indicó el académico. El proyecto consta de dos etapas. La primera, actualmente en curso, está enfocada en la recolección de los datos necesarios para entrenar el modelo. La segunda parte consiste en el entrenamiento de modelos propiamente tal, con la idea de tener un producto funcional en el plazo de dos años.


ARIES
(21 de marzo al 20 de abril)
AMOR: Los sentimientos no se deben transar y menos por personas que no se toman en serio el afecto de los demás. SALUD: Más cuidado con las alzas de presión. DINERO: Tiene que ser mucho más constante o las cosas más tardarán en ser logradas. COLOR: Amarillo. NÚMERO: 5.
TAURO
(21 de abril al 20 de mayo)
AMOR: Ese amor puede ser correspondido, pero a veces es importante que darle tiempo a que las cosas fluyan solas. SALUD: Trate de tomar medidas para eliminar algo de estrés. DINERO: Entregue buenas ideas en su lugar de trabajo, demuestre que puede aportar. COLOR: Lila. NÚMERO: 1.
GÉMINIS
(21 de mayo al 21 de junio)
AMOR: No se rinda si ese corazón se pone algo esquivo, lo importante es ser paciente y sobre todo actuar con sinceridad. SALUD: No conduzca a exceso de velocidad, cuide su vida. DINERO: No aumente su endeudamiento más de la cuenta. COLOR: Negro. NÚMERO: 9.
CÁNCER
(22 de junio al 22 de julio)
AMOR: Puede ser doloso de algún modo, pero alejarse de ciertas personas puede terminar siendo mucho más positivo para su vida. SALUD: Si se confía demasiado la salud podría jugarle una mala pasada. DINERO: A toda costa termine las tareas que inició. COLOR: Blanco. NÚMERO: 38.


8 de julio 2025
LEO
(23 de julio al 22 de agosto)
AMOR: Si tiene dudas analícelas para ver si tiene asidero o no. Tal vez solo sean producto de su temor natural. SALUD: Lograr una armonía entre cuerpo y mente no es fácil, pero usted puede lograrlo si lo intenta. DINERO: No tome a la ligera los problemas de índole legal. COLOR: Plomo. NÚMERO: 10.
VIRGO
(23 de agosto al 22 de septiembre)
AMOR: Si permite que su relación caiga en el abismo por culpa de la rutina. SALUD: Mantener a pesar de todo una actitud positiva será un gran paso para que su organismo también se sienta bien. DINERO: Póngase a trabajar para que esos objetivos se concreten. COLOR: Plomo. NÚMERO: 6.
LIBRA
(23 de septiembre al 22 de octubre)
AMOR: Vea que actitudes le están alejando de las demás personas, así podrá corregirlas. SALUD: Cuando usted sale un poco de la rutina también está favoreciendo a su condición de salud. DINERO: Ahorre, eso es lo más prudente que puede hacer. COLOR: Burdeo. NÚMERO: 23.
ESCORPIÓN
(23 de octubre al 22 de noviembre)
Entregarse por completo es la clave para dejar fluir todo entre ustedes. SALUD: Los problemas al corazón los puede evitar alejándose de los malos hábitos. DINERO: No debe confiarse tanto de algunos consejos de terceros cuando se trata de los negocios. COLOR: Rojo. NÚMERO: 31.

SAGITARIO
(23 de noviembre al 20 de diciembre)
AMOR: No es bueno poner tantas condiciones, eso puede terminar aburriendo a los demás. SALUD: Tome más conciencia y respete más a su organismo. DINERO: Lo importante es planificar ya que al dejar cosas al azar estará aumentando el riesgo. COLOR: Café. NÚMERO: 54.
CAPRICORNIO
(21 de diciembre al 20 de enero)
AMOR: No tiene que permitir que algunas personas abusen de sus sentimientos como si estos no fueran importantes. SALUD: Cuando tiene que ver con la salud nada debe ser al azar. DINERO: Usted puede lograr cosas increíbles, pero le hace falta valor. COLOR: Verde. NÚMERO: 2.
ACUARIO
(21 de enero al 19 de febrero)
AMOR: Deje que sea su encanto el que logre conquistar ese corazón, después de esto ver a la persona maravillosa que es usted. SALUD: Controle un poco el mal genio. DINERO: Cuidado con malgastar sus ahorros, es mejor que los guarde para imprevistos. COLOR: Marrón. NUMERO: 18.
PISCIS
(20 de febrero al 20 de marzo)
AMOR: Mire alrededor suyo y verá todo el efecto que tratan de entregarle las personas que están cerca de usted. SALUD: No consuma tanta comida chatarra ya que le hace mucho daño. DINERO: lo importante es establecer prioridades en sus gastos. COLOR: Granate. NUMERO: 2.
100
HYUNDAI SANTA Fe, año 2009, diésel 2.2cc, $6.270.000 conversable, documentos al día. Fono 987429560 La Calera. KIA RÍO, año 2019, 1.4cc, caja sexta, full equipo, documentos al día, vendo por viaje $8.500.000 conversable. Único dueño fono 974881359 Hijuelas.
PEUGEOT 206, 2009, 1.4, 4 puertas, full equipo, papeles al día, $2.750.000. contacto 999224119
SUZUKI AERIO, año 2004, 223.627 kilómetros, papeles al día, color celeste, $3.300.000 conversable. Contacto 991732289.
CHEVROLET CAPTIVA LTZ 1.5 turbo año 2025, gris grafito, nueva nueva, solo 7mil km, única dueña, real oportunidad a toda prueba, $16.8 millones. Fono 569 74309787.
TOYOTA COROLLA XLI, año 2006, Motor 1.6, al día, color plateado, tapiz impecable, aire acondicionado. Llantas. $3.800.000. Fono 56954140892.
AUTOMÓVIL HYUNDAI Sonata 2001, full equipo, techo electrónico, tapiz, neumáticos nuevos, antiportonazo, $2.390.000 oportunidad. 985722579.
CHERY TIGGO 2, 2022, único dueño, $ 9.490.000. Toyota Yaris, 2013, sedán, $6.490.000. Recibimos vehículo. Fono +56 9-94998176 Cuneo Autos.
CHEVROLET SAIL, 2012, full equipo, $ 4.490.000.- Toyota Tercel, 1997, $ 2.950.000.Fono +56 9-94998176 Cuneo Autos.
CORSA PLUS, 2010, mantención, repuestos nuevos, llantas aluminio, neumáticos, batería nueva, cierre, alarma, motor impecable. Fono 931979963. FIAT UNO, 1.3, año 2004, en buenas condiciones. $1.400.000. Quillota. 965019282.
120 Camionetas y todo terreno venden
PROVINCIAS DE QUILLOTA Y PETORCA
CAMIONETA FORD modelo F-150 limited, año 2021, 75.000 kms., top de la línea, único dueño, color negro, excelentes condiciones, $37.800.000. Contacto 974322675, Quillota.
CAMIONETA GREAT Wall Wingle 6, d.cabina, 2020, impecable, full equipo, como nueva, $9.390.000, recibo. 985722579.
NISSAN TERRANO, 2009, doble cabina, no minera, $4.790.000. Nissan X Trail, 2015, larga, $8.990.000. Great Wall Safe, 2009, station wagon, $5.590.000. Recibimos vehículos. WhatsApp. Fono +56 9-94998176 Cuneo Autos.
130 PROVINCIAS DE QUILLOTA Y PETORCA
Furgones, buses y camiones venden ordenados por marca
CAMIÓN HYUNDAI HD35L, año 2022, $19.500.000, 145000 kilómetros. Interesados llamar +56982814868.
FURGÓN TNT, año 2011, minibús, oferta $3.000.000 conversable. Fono 939064607 La Calera
150 Taxis y otros vehículos venden.
PROVINCIAS DE QUILLOTA Y PETORCA
CHEVROLET SAIL, radiotaxi, 1.4 cc., trabajando, con cupo, 2014, $16.000.000 conversable. Contacto +56993325996.
DEPARTAMENTO EN condominio Altos de Merced. 3 dormitorios, 1 baño, closet, Estacionamiento, 4º piso. Impecable. Frente a Calle Merced. F955367408.
ARRIENDO $320.000 condominio Río Aconcagua, calle Yungay, 2º piso. 2 dormitorios mas uno chico. Fono corredor 979373769.
VENDO MOTOELECTRICA, con techo, poco uso, para 800 kilos, $1.000.000. Interesados 987058837 Pachacamita, La Calera.
MOTO AIDA electrónica, año 2022, 0Kms., documentos al día, por no uso, $790.000 oportunidad. 985722579.
MOTORRAD, AÑO 2022, 498kms, modelo CG150, al día, $850.000 oportunidad, por no uso. 985722579.
MOTO AIDA nueva, 70 kms., 1.600 cc., eléctrica, documentos, 2026, con casco nuevo. Fono 931979963.
PIEZA amoblada, baño privado, independiente, gastos incluidos, cocina, central Quillota. +56971323171.
LA CALERA, arriendo condominio Ravello, lindo departamento 3 dormitorios, estacionamiento, guardias, canón $450.000. Corredor +56983456695.
LA CRUZ, arriendo en condominio Las Palmas, departamento 3 dormitorios, estacionamiento, paradero 14, canón $350.000. Corredor +56983456695.
QUILLOTA ARRIENDO, casa dos pisos, dos dormitorios, patio, entrada auto, lavandería. Villa Paraíso, documentación. +56993274394.
QUILLOTA BOCO, arriendo $250.000, casa 2 dormitorios, patio. Población Díaz Fuenzalida. Contacto 989497275.
SE ARRIENDA departamento nuevo 3D 2B, estacionamiento, bodega, condominio Finka Poniente, $400.000 GGCC incluidos. 56957984548
ARRIENDO CASA nueva, 2 dormitorios, 1 baño, Paradero 8 Quillota $420.000. Corredora 956347339.
ARRIENDO DEPARTAMENTO pequeño Quillota, matrimonio, persona sola, dormitorio mas comedor, cocina, baño, lavadero, patio, +56994352035.
QUILLOTA DEPARTAMENTO a la calle, central, para una persona, $240.000. Teléfono: 964258161.
HABITACIONES AMOBLADAS a empresas, baño privado, estacionamiento, persona sola, internet, lavadora, secadora, cocina, +56982654460. Quillota
LA CALERA, arriendo casa en condominio, Carrera esq/ O´Higgins, frente centro comercial, 2 dormitorios, 2 baños, lavadero techado, patio, estacionamiento, $400.000, no hay gastos comunes. 977084994.
ARRIENDO PIEZA, Población O’Higgins, Quillota. Solo mujeres. Servicios básicos incluidos. $200.000, habitación grande. 965019282
RUCALHUE
Arrienda: 2 locales comerciales: pleno centro La Cruz: excelente ubicación, a metros supermercado Santa Isabel y al lado de Strip center. Recién remodelado. Arriendo por local: UF 16,60 ($650.000.aprox.).Cada Local consta de Sala de ventas, bodega y baño. Superficie 43 m2. No paga gastos comunes y tiene remarcador para agua y luz. Se requiere 1 mes de arriendo 1 mes garantía comisión 50% corretaje. Ingresos demostrables 3 veces el valor de arriendo. Contacto: Pamela Ayala correo payalaoyanedel@gmail.com, fono +56966177482.
Casas y departamentos. 235
VENDO DEPARTAMENTO dos dormitorios, 1 baño. Condominio paradero 6, La Cruz, $78.000.000. Llamar +56957288498.
DOS CASAS en condominio, de 96 y 105 m2, ambas con: 3 dormitorios, 3 baños, cocinas equipadas, living comedor, sala de estar patio y estacionamiento 2 vehículos, 3.950 y 4.190 UF cada una, directo su dueño. 569 74309787.
VENTA CASA El retoño, 3 dormitorios, 1 baño, cocina ampliada, $ 79.000.000 Corredora 956347339.
VENTA CASA Villa Bonifacio, Quillota, cerca hospital Biprovincial, 3 dormitorios, estacionamiento, $110.000.000 Corredora 956347339.
LA CALERA: vendo casa Población Cemento Melón, 5 dormitorios, 3 baños, con local comercial. Interesados llamar +56968536665.
VENDO TERRENO de 6.2 hectáreas sector La Peña La Calera, a pasos de la Ruta 5 (lado Sopraval), cuenta con derechos de agua. Directo dueño 990357095.
245 Locales y propiedades para uso comercial e industrial.
EXCELENTE PROPIEDAD comercial, Caleta Horcón. Restaurant dos pisos, a puerta cerrada, frente a caleta. +56987830114.
255 Corredores de propiedades.
WWW.DISPONIBLESYA.
CL, ENCONTRARAS las propiedades más destacadas para compra, venta, arriendo, además servicios profesionales exprés indispensables para tu proyecto.
PROPIEDADES CARMONA
SERVICIOS DESDE 1980
COMPRA, VENTA, ARRIENDOS Y ADMINISTRACIONES, TASACIONES COMERCIALES, SUBDIVISIONES SAN MARTÍN 321 – RED FIJA FONO 443700983 propiedadescarmona@msn.com
GASFITERIA INSTALACIÓN mantención: calefont, artefactos sanitarios, alcantarillado, fosas sépticas, destapes, termofusión. 921987478.
SERVICIOS EN GENERAL 550
PROVINCIAS DE QUILLOTA Y PETORCA
DIVORCIO. FACILIDADES de pago. Quillota-Abogados. Fono +56 991264805 Email camila. maldo.c@gmail.com

VENDO TERRENO 5.000 mts. Av. Ricardo Santa Cruz 301, Pocochay. Contacto 985796116.
SE VENDE hermosa parcela, ideal para vivir en la zona rural de La Calera, tiene acceso expedito a 10 minutos del centro de la ciudad, y se encuentra en un entorno tranquilo. cuenta con toda la documentación al día. Valor $80.000.000. Para reales interesados que deseen visitar la propiedad, pueden comunicarse al 56994458816 o escribir al siguiente correo electrónico bpsfelipe@gmail. com FOTOS Cód.: 2134610821
VENDO 2 parcelas 5.000 mts., $15.000.000 las dos, Lliu-Lliu. Contacto 994898420. PARCELA 7.800 m2., con casa. 4 dormitorios, baño. Altos de San Pedro, Quillota. $70.000.000. Contacto 958671872.
QUILLOTA VENDO, casa Benimelli 975 Corvi 107,37 m2., living comedor, pasillo, baño, cocina y comedor de diario, caja escala, dos dormitorios, pasillo y baño. Títulos y recepción municipal saneados. Excelente estado. $82.000.000.
QUILLOTA ARRIENDO, casa, Maipú 635, 150 m2., living comedor, cocina y comedor de diario, 3 dormitorios, dos baños, patio de luz, bodega, estacionamiento 3 vehículos, patio exterior. $800.000 mensuales.
PROVINCIAS DE QUILLOTA Y PETORCA
CONSTRUCCIÓN TECHUMBRES, carpintería, tabiques, albañilería, muros, estucos, radier, cerámicos, pintura interior exterior, demoliciones. Presupuesto. 977576019
PROVINCIAS DE QUILLOTA Y PETORCA
IMPORTANTE EMPRESA necesita técnico o ingeniero eléctrico certificado. Enviar curriculum a: info@gruporoman.cl o avalenzuela@gruporoman.cl
SE NECESITA lubricador para lubricentro con real experiencia en aceites y filtros. Dejar currículum Avenida Valparaíso 1910, Quillota. 990012095.
SE NECESITA Chofer para Radiotaxi para La Calera, con recomendaciones. Interesados llamar +56985411289.
SE NECESITA trabajador, atención público, conocimiento en computación, lubricación, filtros y accesorios automotriz. Dejar curriculum Avenida Valparaíso 1910, Quillota. 990012095.
SE NECESITA Electromecánico automotriz, (que realmente ejecute el trabajo de electromecánico), con ganas de trabajar, proactivo, amigo de las herramientas no del celular. Dejar currículum en Josefina 614 La Calera, WhatsApp +56966943509.
AYUDANTES MAQUINARIAS, se necesita contratar Ayudantes de Maquinarias. Trabajo estable. De lunes a viernes y sábado mediodía. No se requiere experiencia previa. Residencia en la comuna de Quillota o alrededores. Enviar currículum a maderasqta@gmail.com
SE NECESITA chofer para auto, uber o radiotaxi. Contacto +56979947014.
SE NECESITA trabajador mayor o jubilado, responsable, campesino, maestro, puertas adentro, para parcela. 9-99026734.
La mejor oferta está en los avisos económicos de EL OBSERVADOR
PROVINCIAS
SE OFRECE señora para cuidado de adulto mayor, con experiencia. Llamar fono 945731702.
SE OFRECE varón responsable, para realizar arreglos menores en vivienda. Contacto +56999330657.
OTROS AVISOS 700
PROVINCIAS DE QUILLOTA Y PETORCA
SE VENDE Sepultura Nueva, liberada de mantención, Parque Quillota, Rauten: Capacidad 4 personas + 3 reducciones.” $5.500.000, llamar al 985954418
TAROT NOEMY, lectura, orientación, numerología. Solicitar hora (33)2517700, +56977690527. Avda. Valparaíso 432, Villa Hermosa, Quillota.
La mejor oferta está en los avisos económicos de EL OBSERVADOR
LEGALES Y PÚBLICOS 750
EXTRACTO. Juzgado de Letras de La Ligua , causa civil Rol V-29-2025 , mediante sentencia de fecha 06-May-2025, SE CONCEDE, LA POSESIÓN EFECTIVA con beneficio de inventario, de los bienes de la herencia testada quedada al fallecimiento de OLGA DEL CARMEN OSSANDÓN OLGUÍN, RUT 6.033.469-2 , bajo el imperio del testamento abierto, otorgada el 04 mayo 2012 ante el Notario Público de La Ligua, en beneficio de MARÍA CRISTINA OSSANDÓN OLGUIN y de MIRELLA OSSANDON OLGUÍN, a quien instituyó como herederas universales de todos sus bienes, incluyendo la cuarta de libre disposición, y cualquier acción o derecho en favor de ella. Procédase a la facción de inventario solemne ante Ministro de Fe del Juzgado de Letras de La Ligua, en audiencia del 17 julio 2025 , a las 10:00 horas, en dependencias del Tribunal, ubicado en Esmeralda 650, La Ligua.
CITACIÓN LA Asociación de Canales CALLE LARGA Y POCOCHAY, cita a Junta General Ordinaria de Accionistas, el Martes 08 de Julio 2025, a las 15:00 horas, Av. 21 de Mayo Nº 3593 (Rotary), La Cruz, en 1era. Citación. Si no hubiera quórum, la sesión se llevará a efecto el mismo día a las 15:30 hrs. en 2da. Citación, con el número de Accionistas que concurra.Tabla a tratar: 1.- Lectura acta anterior; 2.- Memoria del presidente; 3.- Cuenta Entradas y Gastos; 4.- Fijar Valor Cuotas Período 2025-2026; 5.- Elección de Directorio para el Período 2025-
2026 y 2026-2027, 6.- Varios. Atentamente, EL DIRECTORIO
CITACIÓN: SEÑOR Socio: La Comunidad de Aguas Canal Pequenes cita a Junta General Extraordinaria de accionistas para el día 23 de julio de 2025 en el RESTAURANT ?DON NICO?, a las 18:00 horas en primera citación y a las 18:30 horas en segunda citación, llevándose a cabo la reunión con los accionistas que se encuentren presentes. TABLA: a) Memoria del presidente del Canal b)Flujo de Caja 2024 c)Presupuesto 2025 ? 2026 d) Elección del Directorio 2025-2026. La Directiva. LA A.G. Cámara de Comercio y Turismo La Calera, cita a sus socios a asamblea general ordinaria para el día viernes 11 de julio de 2025 a las 19:30 horas, en primera citación y 19:45 en segunda citación en su sede Aldunate Nº141. Atentamente. El Directorio.
ORDEN NO pago por extravío cheques Nº 2301089 hasta Nº 2301099, cuenta corriente Nº 23300040781, Banco estado, sucursal Quillota.
COOPERATIVA APR Mirador de Los Molles: Cita a Junta General de Socios según el Artículo 44 de los Estatutos, en segunda citación para el 12 de julio de 2025, a las 17:00 Horas en Parcela 42 del Mirador de Los Molles, La Ligua. Tabla. 1.- Informe de Gestión año 2024. 2.Informe de la Comisión Revisora de Cuentas. 3.- Manipulación de matrices y llaves de paso de la cooperativa. 4.- Racionamiento y Cuotas de Agua. 5.- Situación de clientes morosos y que no pagan a tiempo. 6.- Varios. La Directiva.
EXTRACTO NOTIFICACIÓN : Juzgado de Familia de La Ligua. Vicuña Mackenna Nº 268, La Ligua, causa RIT C-379-2024
sobre Alimentos, Aumento, caratulada “LÓPEZ/HURTADO”, seguida ante Juzgado de Familia de La Ligua, por resolución de fecha 09 de mayo de 2025, se ha ordenado notificar por avisos a la parte demandada PABLO IGNACIO HURTADO OLIVARES, RUN N º 15360791-5, de la demanda, su proveído y resolución de 09 de mayo de
2025. DEMANDA: DEMANDA DE AUMENTO DE ALIMENTOS; PRIMER OTROSÍ: AUMENTO PROVISORIO DE ALIMENTOS; SEGUNDO OTROSÍ: ACOMPAÑA DOCUMENTOS; TERCER OTROSÍ: FORMA NOTIFICACIÓN; CUARTO OTROSÍ: PRIVILEGIO POBREZA; QUINTO OTROSÍ: PATROCINIO Y PODER; SEXTO OTROSÍ: COMPARECENCIA
• Otro foco relevante del trabajo apuntó al control de los sectores de mayor impacto en el sistema tributario, como los Grupos Empresariales y Multinacionales y los Contribuyentes de Altos Patrimonios, y la aplicación de la Norma General Antielusiva. Esto, considerando que, en materia de recaudación, por ejemplo, el segmento de Grandes Empresas representa el 67,56% del total, por lo que el SII destinó el 33,35% de las horas dedicadas a la fiscalización, a pesar de que representan solo un 0,42% del total de contribuyentes.
• En la lucha contra el crimen organizado, los énfasis han estado en el comercio informal, el robo y comercialización del salmón, y las redes dedicadas al robo de vehículos, sus partes y piezas.
• El Director del SII destacó que los resultados alcanzados solo son posibles gracias a los 5 mil funcionarios que se despliegan diariamente a lo largo del país para fiscalizar y facilitar el cumplimiento tributario, desplegando su reconocida vocación de servicio público.
En su Cuenta Pública 2025, el Director del SII, Javier Etcheberry, destacó como focos relevantes de la gestión del Servicio durante 2024 la estrategia de fiscalización para disminuir la evasión y el combate contra el fraude, el delito tributario y el crimen organizado.
En la ocasión, la autoridad relevó que “Chile sigue enfrentando brechas relevantes de cumplimiento tributario que afectan a empresas de distintos tamaños y diferentes sectores de la economía”, agregando que, en ese contexto, “el SII tiene también un rol crucial en el impulso del crecimiento económico y la modernización del país”. En este sentido, destacan los resultados alcanzados gracias a la focalización de las acciones de control en los sectores de mayor impacto en el sistema tributario, lo que se realiza de manera paralela a los controles de cumplimiento tributario en terreno que despliega la institución a lo largo del país.
Etcheberry destacó como otro punto central de su gestión, la colaboración del SII con organismos públicos y privados, nacionales e internacionales para asegurar el cumplimiento tributario, apoyar en el combate de la corrupción, el crimen organizado, carteles y mafias.
Respecto de la asistencia y facilitación al contribuyente, el SII se plantea como desafíos la implementación de ajustes y mejoras a procesos internos como las peticiones administrativas, para mejorar la comunicación con el contribuyente, incrementando la calidad y disminuyendo los tiempos de las respuestas; la revisión de la actuación fiscalizadora (RAF), donde se entregaron orientaciones a los equipos regionales para considerar la admisibilidad de estos recursos ante errores propios de los contribuyentes, especialmente de personas o pequeñas empresas; y la administración del impuesto territorial, priorizando los principales problemas para abordarlos en forma inmediata y entregar información transparente a los contribuyentes respecto del avalúo de sus propiedades, a partir del Reavalúo No Agrícola en 2026.
Por último, se fortalecerán las coordinaciones con los Colegios de Contadores, Colegio de Abogados y otras Organizaciones Gremiales para abordar sus inquietudes y consultas, y así facilitar y asegurar los derechos de los contribuyentes que cumplen con sus obligaciones tributarias.
Finalmente, el Director del SII destacó que los resultados alcanzados solo son posibles gracias a los 5 mil funcionarios que se despliegan diariamente a lo largo del país para fiscalizar y facilitar el cumplimiento tributario, desplegando su reconocida vocación de servicio público.

LEGALES Y PÚBLICOS 750
Viene de página anterior posible trastorno de déficit atencional, alumna del colegio Pehuén de Cabildo. Renata, asiste al Jardín Infantil Rinconcito que es de la JUNJI en nivel medio mayor. Por la edad de las niñas cada vez incurre en más gastos, ambas viajan en furgón escolar, $43.000 pesos por María Julieta y $40.000.- pesos por Renata. Además, mantiene gasto mensual de $200.000 por persona que cuida a las niñas, paga arriendo por $200.000.- mensuales y el canon ha subido más de $40.000, a lo que debe sumarse gastos de mantención del hogar, educacionales y de alimentación, además, el demandado, no ha cubierto los gastos extraordinarios de las niñas. Su grupo familiar se compone por la demandante y ambas niñas, quien mantiene ingreso por
REMOTA. MARÍA FRANCISCA LÓPEZ SAAVEDRA, RUN 16.777.968-9, interpone demanda contra PABLO IGNACIO HURTADO OLIVARES, RUN 15.360.791-5. HECHOS: Ambos padres de MARÍA JULIETA y RENATA IGNACIA, HURTADO LÓPEZ. Existe pensión de alimentos acordada en causa RIT C-476-2023 de este Tribunal por el monto de 3,23787 UTM, lo que es insuficiente para cubrir gastos de las niñas unido a la variación de circunstancias desde que se fijaron. María Julieta, diagnosticada en septiembre el año 2023 con TEA grado 1, asiste sesiones con psicóloga de Hospital de Cabildo con

sobre el mínimo legal. Por su parte el demandado tiene mejores capacidades que al momento en que se fijó la pensión alimenticia 2023, no tiene más hijos y se desempeña como trabajador dependiente unido a que la pensión de alimentos acordada, actualmente, es inferior al mínimo legal por dos hijos. POR TANTO: interpone demanda de aumento, solicitando a S.S, acogerla en todas sus partes decretando el aumento de la pensión de alimentos vigente a una suma no inferior a un 60% del I.M.M.R. actualmente $300.000, más el 50% de los gastos extraordinarios, o a la suma que S.S. estime proceda
en justicia, todo ello mediante la modalidad de retención por el empleador, si así procediere.
DA CURSO : La Ligua, diez de octubre de dos mil veinticuatro.
A LO PRINCIPAL: Por interpuesta demanda de Alimentos Aumento. Traslado. La audiencia se celebrará con las partes que asistan, afectándole a la que no concurra todas las resoluciones que se dicten en ella sin necesidad de ulterior notificación, según lo dispone el artículo 59 de la Ley Nº 19.968 de Tribunales de Familia. Las partes deberán concurrir personalmente a la audiencia preparatoria y a la
Continúa en página siguiente

Viene de página anterior preparatoria. Si desea reconvenir, deberá hacerlo de la misma forma, juntamente con la contestación de la demanda cumpliendo con los requisitos establecidos en el artículo 57 de la Ley Nº 19.968 de Tribunales de Familia. Se hace presente a ambas partes que deberán acompañar en la audiencia preparatoria sus liquidaciones de sueldo, copia de la declaración
audiencia de juicio, patrocinadas por abogado habilitado para el ejercicio de la profesión y representadas por persona legalmente habilitada para actuar en juicio. Las partes deberán manifestar en la audiencia preparatoria los medios de prueba de que piensan valerse en la audiencia de juicio, indicando los documentos, testigos y otras pruebas a ofrecer. Para el caso de ofrecer prueba de testigos y peritos, deberán indicar el nombre completo, profesión u oficio y domicilio de éstos. Si desean solicitar oficios a instituciones, deberán indicar clara y pormenorizadamente el domicilio de cada una de las instituciones, bajo apercibimiento de tener por no solicitada la diligencia. Se hace presente a la parte demandada que, si no dispusiere de los medios suficientes para costear su defensa, deberá concurrir dentro de los 05 días siguientes a la notificación de la presente resolución a la Corporación de Asistencia Judicial de esta ciudad, para que asuma su representación, previa calificación, debiendo acompañar antecedentes que acrediten su actual situación socioeconómica. En todo caso, si el demandado comparece a la audiencia preparatoria sin asistencia letrada, se entiende que renuncia a ella y la respectiva audiencia se realizará indefectiblemente. La parte demandada deberá contestar la demanda por escrito, con al menos 5 días de anticipación a la fecha de realización de la audiencia
de impuesto a la renta del año precedente y copia de las boletas de honorarios emitidas durante el año en curso y demás antecedentes que sirvan para determinar su patrimonio y capacidad económica. En el evento que no disponga de tales documentos, acompañará o extenderá en la propia audiencia, una declaración jurada en la cual dejará constancia de su
patrimonio y capacidad económica. La declaración de patrimonio deberá señalar el monto aproximado de sus ingresos ordinarios y extraordinarios, individualizando lo más completamente posible, si los tuviere, sus activos, tales como bienes inmuebles, vehículos, valores, derechos en comunidades o

Viene de página anterior
LEGALES Y PÚBLICOS 750
sociedades. El ocultamiento de cualquiera de las fuentes de ingreso del demandante, efectuado en juicio en que se exija el cumplimiento de la obligación alimenticia, será sancionado con la pena de prisión en cualquiera de sus grados. La parte que no acompañe todos o algunos de los documentos requeridos o no formule la declaración jurada, así como el que presente a sabiendas documentos falsos, y el tercero que le proporcione maliciosamente documentos falsos o inexactos o en que se omitan datos relevantes, con la finalidad de facilitarle el ocultamiento de sus ingresos, patrimonio o capacidad económica, serán sancionada con las penas del artículo 207 del Código Penal. La parte demandada deberá informar al tribunal todo cambio de domicilio, de empleador y de lugar en que labore o preste servicios, dentro de treinta días contados desde que el cambio se haya producido, el demandado que no dé cumplimiento a lo anterior se le impondrá una multa de 1 a 15 unidades tributarias mensuales, a beneficio fiscal. AL PRIMER OTROSÍ: Traslado: RESOLUCIÓN 09-05-2025: La Ligua, nueve de mayo de dos mil veinticinco. Atendida a la presentación formulada por la parte demandante, teniendo en consideración la proximidad de la audiencia, y de conformidad a lo dispuesto en el artículo 13 de la ley Nº 19.968, se resuelve: Se reprograma la audiencia fijada para el día 28 de mayo próximo, y se fija para su conti -
nuación, la del día 11 de agosto de 2025, a las 10:00 horas, sala N º 2, DE FORMA PRESENCIAL Para los efectos del artículo 60 bis de la Ley 19.968, las partes deberán solicitar autorización al tribunal a través de la Oficina Judicial Virtual (OJV) hasta dos días antes de la realización de la audiencia, ofreciendo algún medio de contacto oportuno, tales como número de teléfono o correo electrónico y conectar a la sala de audiencia virtual el día fijado con 10 minutos de anticipación, indicando su nombre, apellido y la calidad en que comparecen, teniendo a mano su cédula de identidad para ser aceptado por funcionario acta, optimizando el tiempo del bloque asignado. El ID y link para conexión en SALA 2; https://zoom. us/j/97162746298 ID de reunión: 971 6274 6298 Sin Código de acceso. Para hacer más eficiente las notificaciones, se apercibe a las partes, a proporcionar una casilla de correo electrónico como forma de notificación especial, bajo apercibimiento de notificar toda ulterior resolución por el estado diario, conforme lo dispone el artículo 23 de la Ley 19.968. Esta obligación deberá cumplirse al momento de efectuar cualquier presentación en la causa. En caso de requerir más información, utilice los canales de comunicación dispuestos por el tribunal: Plataforma: Canal Digital PJUD A través del enlace: https://conecta.pjud.cl Correo electrónico del Tribunal jflaligua@pjud.cl Teléfono: (33) 2714002/(33) 2714091. Notifíquese la presente resolución a la demandante por correo electrónico. Notifíquese al demandado de la demanda, su
proveído y la presente resolución por avisos, al tenor de lo dispuesto en el artículo 54 del Código de Procedimiento Civil. Dirigió la audiencia y resolvió Juez/a del Juzgado de Familia de La Ligua. Carolina Mercado Ramírez Jefa de Unidad – Ministra de Fe(S) Juzgado de Familia de Ligua.
EXTRACTO : REMATE , ante Juez Partidor, don Javier Infante Martín, correo electrónico arbitrojavierinfante@gmail.com, el 30 de julio de 2025 a las 17:00, se rematará por video conferencia inmueble ubicado en Luis Cruz Martínez 248, Población Los Héroes de la Concepción de la comuna de La Calera, rola inscrito a fojas 5658 Nº 2907 y a fojas 5659 Nº 2909, ambos del Registro de Propiedad del año 2019 del Conservador de Bienes Raíces de a Calera, Rol 238-4, La Calera. El mínimo de posturas 4.315 unidades de fomento, precio pagadero al contado 20 días hábiles posteriores a subasta. Para hacer posturas interesados deberán
presentar caución, sea en vale vista o consignación en cuenta corriente don Javier Infante Martín, por 431,5 unidades de fomento, en equivalente en pesos. El link para conectarse a subasta se enviará a quienes hayan efectuado caución de forma antedicha. Postulantes deben acreditar no estar inscritos en Registro de Deudores de Pensiones de Alimentos. Demás bases en expediente juicio arbitral ZAMORA con ZAMORA. Ministro de Fe. 4º Juzgado Civil de Valparaíso. En causa Rol V-11-2025, por sentencia de fecha 20 de mayo de 2025, se concedió la posesión efectiva de la herencia intestada, quedada al fallecimiento de don LINCOYÁN ENRIQUE INOSTROZA MUÑOZ, C.I. 5.606.730-2, fallecido el 21 de marzo de 2023, a su cónyuge, doña IRMA JUDITH ROGEL GALLARDO RUT 6.506.5436, y a don PATRICIO EDUARDO INOSTROZA ROGEL RUT 12.845.863-8, en su calidad de hijo. Secretaria (S).

